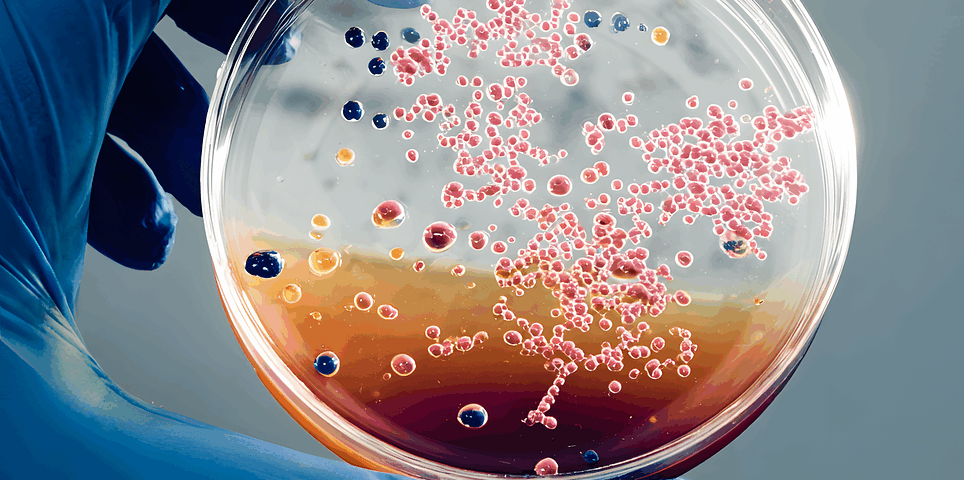

EUROPE – COM: Update of the Guidance Document for virus-containing PPP Authorisation
23 March 2026
FRANCE: Publication of the list of priority plant protection uses
14 April 2026The Commission has published an update of guidance document SANCO/12823/2012 for the assessment of the equivalence of “microbial pest control agent as manufactured”, in the framework of Regulation (EC) No 1107/2009. This 5th version applies to applications submitted from 11 March 2026 onwards.
This new version does not introduce any significant technical change, but it complies with Regulation (EU) No 283/2013, as updated by Regulation (EU) No 2022/1439 of 31 August 2022, which sets out the information requirements for microbial active substances.
A technical equivalence assessment is required in the context of a change in at least one of the following manufacturing aspects:
- location of manufacturing plant or addition of another location,
- scale up of fermentation vessel,
- change of manufacturing process, like change of production equipment or propagation conditions (e.g. temperature, ingredients or isolates in case of baculoviruses and bacteriophages).
Moreover, the technical equivalence assessment report template has been updated in the guidance document.
To download:
SANCO/12823/2012 (11/03/2026)
See also our previous articles:
EUROPE: New rules for micro-organisms
Lynxee consulting’s team is at your disposal to answer your questions.
Contact us! http://lynxee.consulting/en/contact/